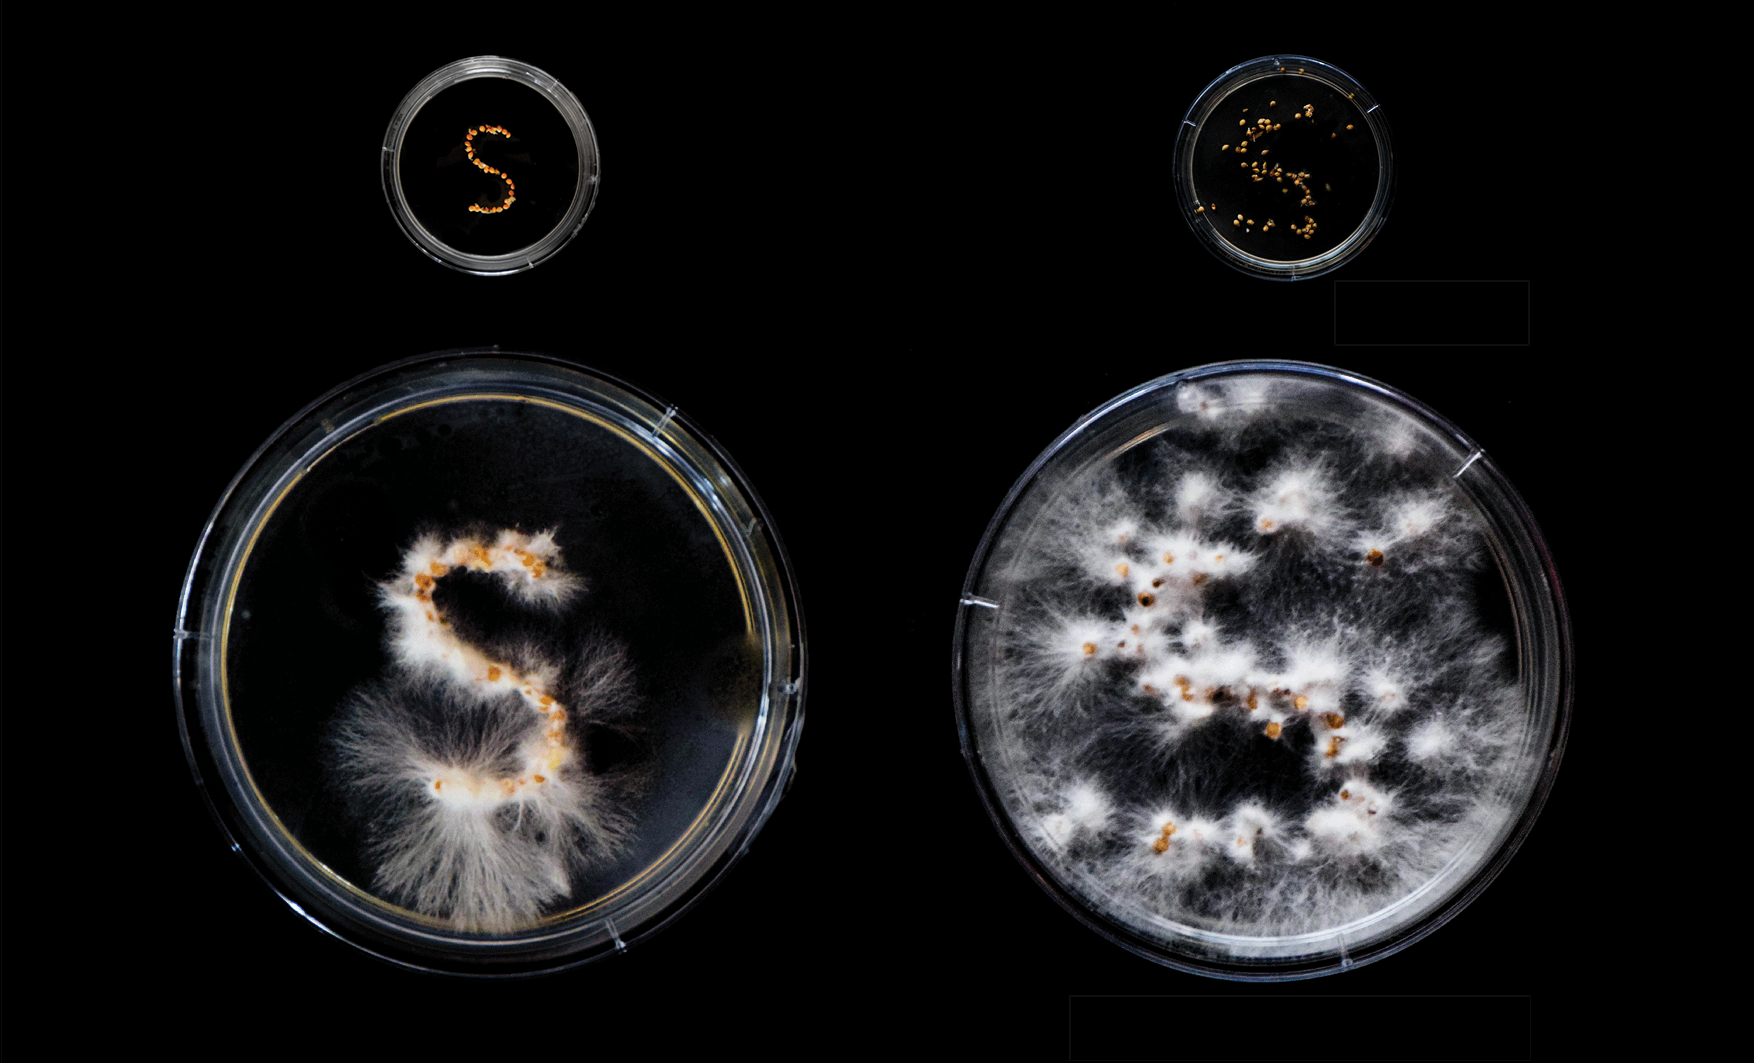

1. Mycelium Cultivation Typography
Exploring the possibilities of creating a new typeface through the process of biomimicry, drawing inspiration from the functions and processes observed in the first stage of mushroom growth (the development of mycelium).
2. Mushroom Kit Grid System
How might observing the stages of mushroom growth from spore germination to mature fruiting bodies be emulated and adapted into creating a grid system? This approach is inspired by nature and seeks to leverage the efficiency and effectiveness seen in natural growth to enhance the rules for organisation and layout of content in a grid system.


︎︎︎Experimental Log 2
︎︎︎Extended Methodology
3. Mycelium Formation Radial Layout
Investigating the unique structure and formation of the mycelium network as inspiration to develop a new, unconventional layout structure, distinct from the standard grid layout commonly used in visual design.


︎︎︎Experimental Log 3A
︎︎︎Experimental Log 3B
︎︎︎Extended Methdology
Visual Communication Honours Project by
Stella Li at the University of Technology Sydney.
Stella Li at the University of Technology Sydney.
Mentored by Monica Monin, 2023.